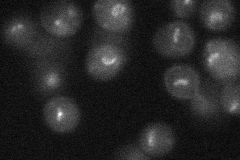
YLR141W

View description
Protein involved in transcription of rDNA by RNA polymerase I; transcription factor, member of UAF (upstream activation factor) family along with Rrn9p and Rrn10p
Localization:
Intensity:
Fold change:
Significance:
-
C’ GFP library in SD

nucleolus19.33 -
N' NOP1pr-GFP in SD

nucleus,nucleolus54.6309 -
N' TEF2pr-mCherry in SD

nucleus,nucleolus27.1865 -
N' NATIVEpr-GFP in SD
punctate23.9115 -
N' TEF2pr-VC and Cyto-VN in SD

below threshold25.7015 -
C’ GFP library in SD+DTT

nucleolus17.040.88No -
C’ GFP library in SD+H2O2

nucleolus18.960.98No -
C’ GFP library in Starvation Media

nucleolus27.331.41No -
C’ GFP library on the background of Pup2-DaMP

nucleolus -
C’ GFP library on the background of CCT mutant

nucleolus23.31251.20522No
